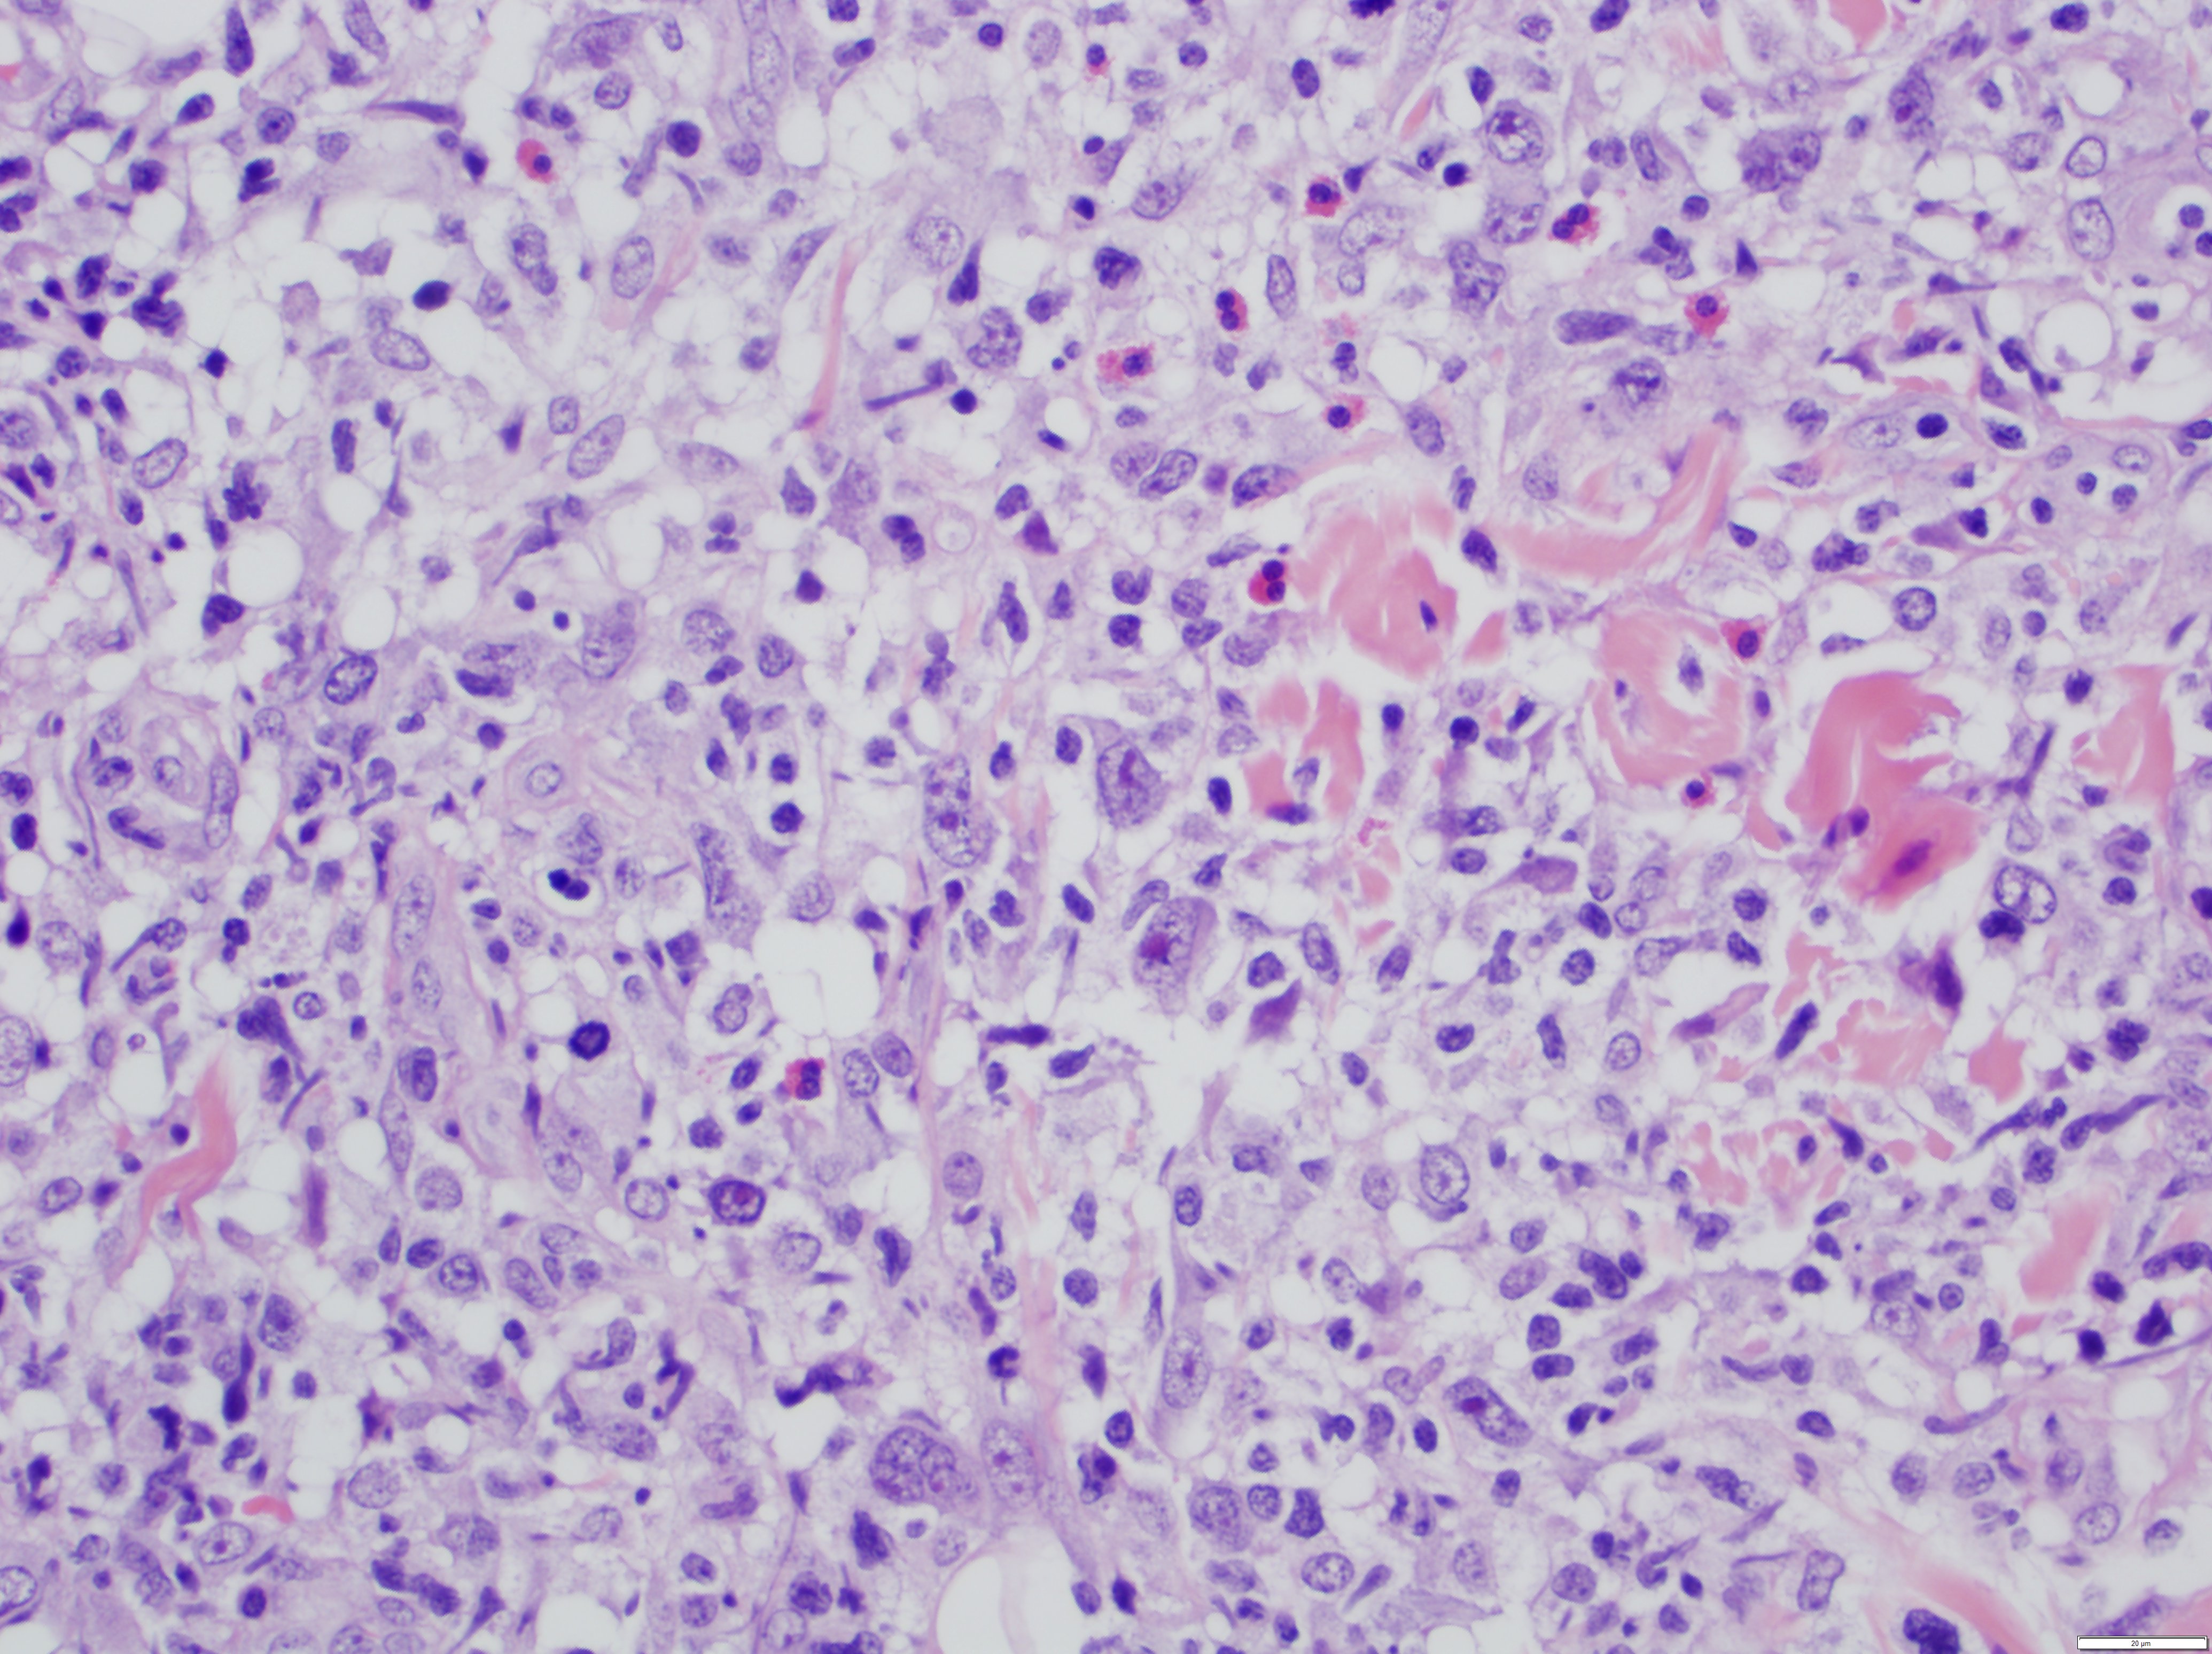
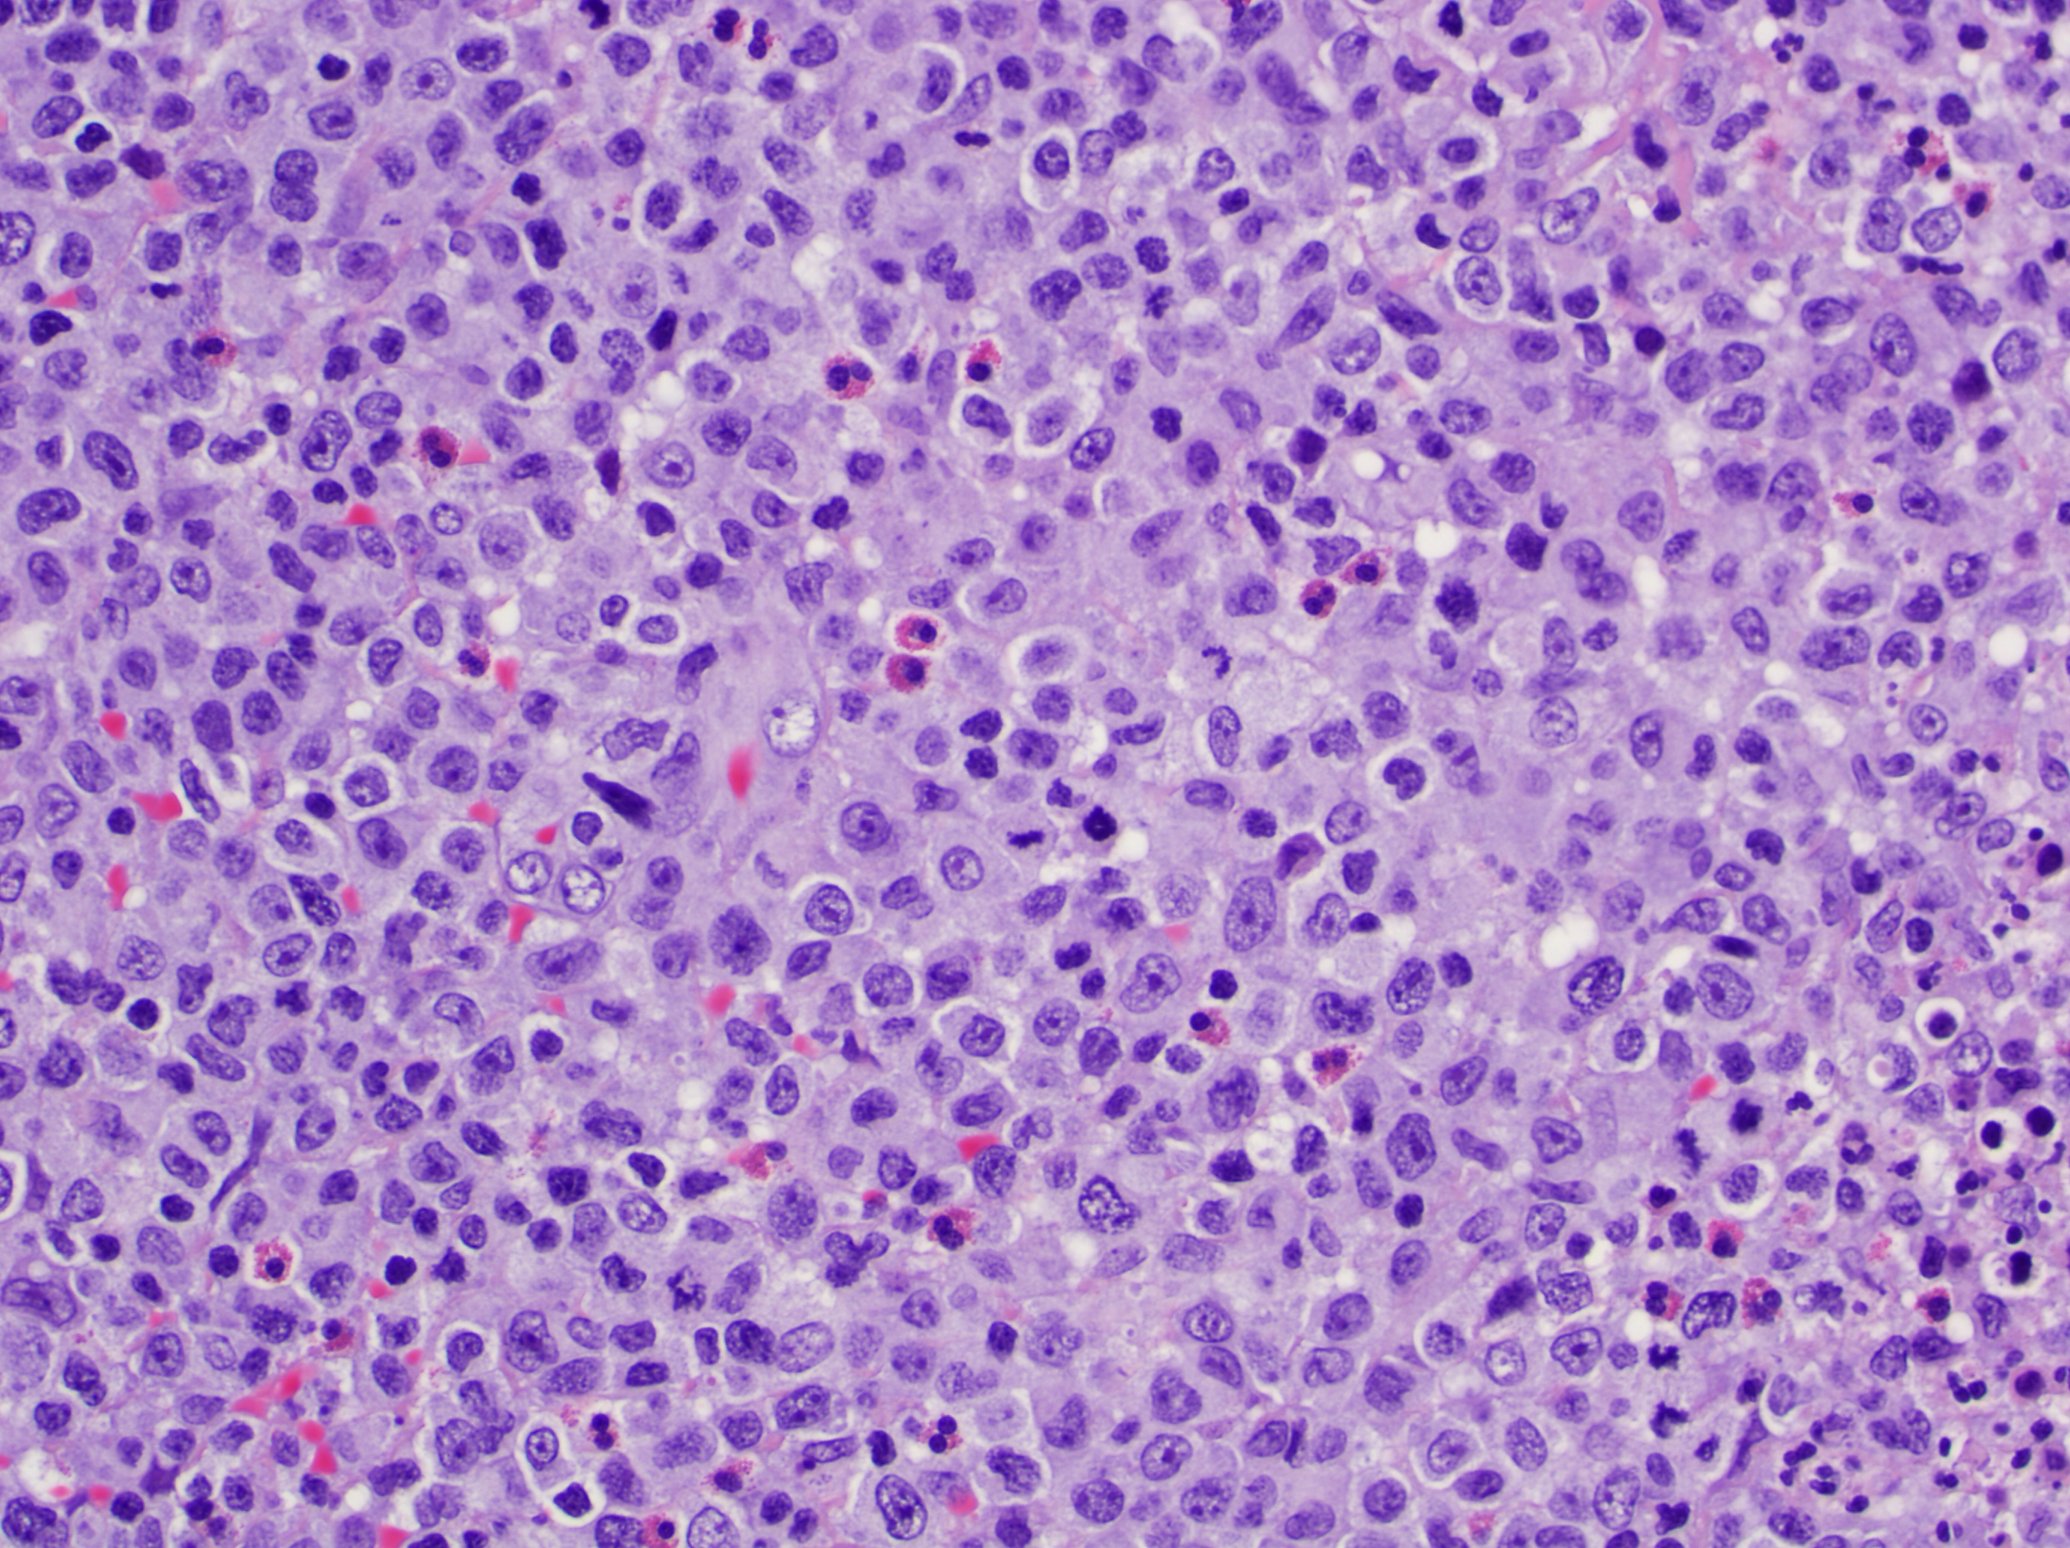

Table of Contents
Definition / general | Essential features | ICD coding | Epidemiology | Sites | Etiology | Clinical features | Diagnosis | Prognostic factors | Case reports | Treatment | Clinical images | Microscopic (histologic) description | Microscopic (histologic) images | Positive stains | Negative stains | Immunohistochemistry & special stains | Molecular / cytogenetics description | Sample pathology report | Differential diagnosis | Additional references | Practice question #1 | Practice answer #1 | Practice question #2 | Practice answer #2Cite this page: Marques-Piubelli M, Ferrufino-Schmidt M, Miranda R. Lymphomatoid papulosis. PathologyOutlines.com website. https://www.pathologyoutlines.com/topic/skintumornonmelanocyticlymphomatoidpapulosis.html. Accessed September 12th, 2025.
Definition / general
- Lymphomatoid papulosis (LyP) is a chronic and self healing CD30+ lymphoproliferative disorder characterized by recurrent erythematous papules / nodules on skin (J Am Acad Dermatol 2016;74:59, Blood 2019;133:1703, Am J Clin Dermatol 2016;17:319, J Clin Oncol 2015;33:3759, Semin Diagn Pathol 2017;34:22, Am J Surg Pathol 2013;37:1173, Blood 2000;95:3653)
Essential features
- Lymphomatoid papulosis (LyP) is a chronic and self healing CD30+ lymphoproliferative disorder characterized by recurrent erythematous papules / nodules on skin; as such it conveys a benign clinical course (J Am Acad Dermatol 2016;74:59, Blood 2019;133:1703, Am J Clin Dermatol 2016;17:319, J Clin Oncol 2015;33:3759, Semin Diagn Pathol 2017;34:22, Am J Surg Pathol 2013;37:1173, Blood 2000;95:3653)
- More common in trunk and extremities but can affect any body part (J Am Acad Dermatol 2016;74:59, Am J Clin Dermatol 2016;17:319)
- Single or clustered red or purple papules and small nodules (< 2.0 cm) with different stages of development; spontaneous regression in few weeks and indolent clinical course (Hematol Oncol 2019;37 Suppl 1:43, J Am Acad Dermatol 2016;74:59, Arch Dermatol 2009;145:966, Semin Diagn Pathol 2017;34:22, Clin Exp Dermatol 2018;43:137)
- Most patients don’t require specific treatment (J Am Acad Dermatol 2016;74:59, Am J Surg Pathol 2013;37:1173, Clin Exp Dermatol 2018;43:137, Blood 2000;95:3653)
ICD coding
- ICD-O: 9718/1 - lymphomatoid papulosis
Epidemiology
- Primary cutaneous CD30+ lymphoproliferative disorders include primary cutaneous anaplastic large cell lymphoma and lymphomatoid papulosis and account for 25% of all cutaneous T cell lymphomas (Hematol Oncol 2019;37 Suppl 1:43, Semin Diagn Pathol 2017;34:22)
- Rare condition in general population and has an incidence of 1.2 to 1.9 cases per 1 million people (Cancer 1992;70:2951)
- Incidence peaks in the fifth decade but can affect all age groups (J Am Acad Dermatol 2012;66:928, J Am Acad Dermatol 2016;74:59, Am J Clin Dermatol 2016;17:319)
- M > F (J Am Acad Dermatol 2012;66:928, J Am Acad Dermatol 2016;74:59)
- In general is more common in Caucasians (Semin Diagn Pathol 2017;34:22)
- Lymphomatoid papulosis type B is more common in Hispanics (J Am Acad Dermatol 2016;74:59)
Sites
- More common in trunk and extremities but can affect any body part (J Am Acad Dermatol 2016;74:59, Am J Clin Dermatol 2016;17:319)
- Oral and mucosal involvement is rare (Semin Diagn Pathol 2017;34:22)
Etiology
- No etiologic factors identified (e.g., not associated with EBV)
- One case report associated with HTLV-1 (Eur J Dermatol 2016;26:194)
- Some cases that show progression to anaplastic large cell lymphoma show resistance to CD30 ligand and mutations of TGF-β (Semin Diagn Pathol 2017;34:22)
Clinical features
- Most patients are previously asymptomatic and lack underlying disease; a subset of cases arises in patients with history of mycosis fungoides
- Clusters of red or purple papules and small nodules (< 2.0 cm each) with different stages of development, spontaneous regression in few weeks and indolent clinical course (Hematol Oncol 2019;37 Suppl 1:43, J Am Acad Dermatol 2016;74:59, Arch Dermatol 2009;145:966, Semin Diagn Pathol 2017;34:22, Clin Exp Dermatol 2018;43:137)
- Less commonly, single or multiple crops; the disease can persist from several weeks to years (J Am Acad Dermatol 2016;74:59, Semin Diagn Pathol 2017;34:22, Clin Exp Dermatol 2018;43:137)
- The severity of lesions is defined as: mild (< 12 lesions), moderate (12 - 50 lesions) and severe (> 50 lesions) (J Am Acad Dermatol 2016;74:59)
- Dermoscopic appearance may coexist in different stages of progression and involution (J Eur Acad Dermatol Venereol 2018;32:e198, Arch Dermatol 2009;145:966):
- Pinkish or light brown papules with homogeneous areas and delicate dotted vascular pattern in the periphery
- Papules with centripetal and tortuous irregular vessels
- Crusts and papules with central scale and vascular pattern sparing the center in mature lesions
- Papule with central necrotic ulceration denotes old lesion
- Post inflammatory pigmentation macule
- Pruritus is the primary symptom in about half of patients (J Am Acad Dermatol 2016;74:59)
Diagnosis
- The correct diagnosis requires (J Am Acad Dermatol 2016;74:59, Am J Clin Dermatol 2016;17:319, Semin Diagn Pathol 2017;34:22, Blood 2000;95:3653):
- A clinical history of crops of lesions with spontaneous regression
- Typical histological findings
- Typical immunohistochemical findings
Prognostic factors
- Excellent prognosis (Hematol Oncol 2019;37 Suppl 1:43, Semin Diagn Pathol 2017;34:22, J Am Acad Dermatol 2012;66:928, Blood 2000;95:3653)
- Around 5% of patients die of disease over a median period of 4 years, particularly those patients with underlying cutaneous lymphoma (J Am Acad Dermatol 2016;74:59)
- Histologic types do not have prognostic significance (Blood 2019;133:1703)
- Clinical follow up is recommended, since there is a risk of developing a second lymphoid malignancy (e.g. mycosis fungoides and Hodgkin lymphoma) (Hematol Oncol 2019;37 Suppl 1:43, J Clin Oncol 2015;33:3759, Semin Diagn Pathol 2017;34:22, Clin Exp Dermatol 2018;43:137, J Am Acad Dermatol 2012;66:928, Blood 2000;95:3653)
- Patients with T cell receptor gene rearrangement or a mixed type of lymphomatoid papulosis have a higher risk of progressing to lymphoma (J Am Acad Dermatol 2012;66:928)
- Men, lymphomatoid papulosis type B and lymphomatoid papulosis type C are associated with increased risk of lymphoma development (J Am Acad Dermatol 2016;74:59)
- Lymphomatoid papulosis type A and lymphomatoid papulosis type D are less frequently associated with lymphoma development (J Am Acad Dermatol 2016;74:59)
- Lymphomatoid papulosis type A is the more prevalent subtype associated with early relapse (Clin Exp Dermatol 2018;43:137)
Case reports
- 7 year old girl with lymphomatoid papulosis type A and pseudocarcinomatous hyperplasia (J Cutan Pathol 2016;43:430)
- 14 year old girl with lymphomatoid papulosis type C of the eyelid (Orbit 2014;33:395)
- 27 year old man with extensive lymphomatoid papulosis type A (Case Rep Dermatol Med 2019;2019:1765210)
- 46 year old woman with Waldenström macroglobulinemia and lymphomatoid papulosis (J Dermatol 2005;32:132)
- 46 year old woman with γδ lymphomatoid papulosis type D mimicking primary cutaneous γδ T cell lymphoma (JAAD Case Rep 2019;5:264)
- 70 year old man with rheumatoid arthritis and lymphomatoid papulosis type E preceding and coexisting with mycosis fungoides (J Cutan Pathol 2015;42:1018)
- 84 year old man with chronic lymphocytic leukemia / small lymphocytic lymphoma and lymphomatoid papulosis type A (Dermatol Online J 2018;24:6)
Treatment
- Most patients don’t require specific treatment (J Am Acad Dermatol 2016;74:59, Am J Surg Pathol 2013;37:1173, Clin Exp Dermatol 2018;43:137, Blood 2000;95:3653)
- Treatments aimed towards symptom relief and faster regression:
- Psoralen ultraviolet A (PUVA) (Hematol Oncol 2019;37 Suppl 1:43, J Am Acad Dermatol 2016;74:59, Clin Exp Dermatol 2018;43:137, Blood 2000;95:3653)
- Related to longer disease free survival (DFS): 10 to 36 months (Clin Exp Dermatol 2018;43:137)
- Topical corticosteroids (J Am Acad Dermatol 2016;74:59, Clin Exp Dermatol 2018;43:137, Blood 2000;95:3653)
- Brentuximab vedotin is an active and well tolerated option and has 100% response rate (J Am Acad Dermatol 2016;74:59, J Clin Oncol 2015;33:3759)
- Bexarotene (J Am Acad Dermatol 2016;74:59)
- Low dose methotrexate (Hematol Oncol 2019;37 Suppl 1:43, Clin Exp Dermatol 2018;43:137)
- Psoralen ultraviolet A (PUVA) (Hematol Oncol 2019;37 Suppl 1:43, J Am Acad Dermatol 2016;74:59, Clin Exp Dermatol 2018;43:137, Blood 2000;95:3653)
Clinical images
Microscopic (histologic) description
- Lymphomatoid papulosis is characterized by a wedge shaped pattern, with a wide superficial base and the tip at the bottom, usually deep dermis and less frequently into the subcutaneous tissue
- The most characteristic appearance is the presence of few to numerous large cells with a Hodgkin or Hodgkin-Reed Sternberg admixed with a reactive background of small lymphocytes and less frequently eosinophils, plasma cells and histiocytes
- The microscopic appearance and immunophenotype of large cells is variable and led to subclassification of lymphomatoid papulosis into different categories (J Am Acad Dermatol 2016;74:59, Blood 2019;133:1703, Semin Diagn Pathol 2017;34:22, J Am Acad Dermatol 2013;68:809, J Am Acad Dermatol 2012;66:928, Am J Clin Pathol 2003;119:731, Am J Surg Pathol 2010;34:1168, Am J Surg Pathol 2013;37:1)
- Type A: wedge shaped and extensive lymphoid infiltrate with neutrophils, eosinophils and histiocytes; CD30+ cells are scattered and the overall histologic appearance mimics classic Hodgkin lymphoma
- Type B: epidermotropism and band-like distribution of small to medium atypical lymphocytes with cerebriform nuclei, without CD30+ expression and mimics mycosis fungoides, patch stage
- Type C: sheets of large cells, uniformly positive for CD30, with or without epidermotropism and few admixed inflammatory cells; the lesion mimics primary cutaneous anaplastic large cell lymphoma
- Type D: atypical small to medium lymphoid infiltrate with epidermotropism; the neoplastic cells express CD30 and CD8 and mimic pagetoid reticulosis
- Type E: angiocentric and angiodestructive pleomorphic lymphoid infiltrate of small to medium size lymphocytes; there are scattered large cells, positive for CD30 and the overall appearance is that of an aggressive lymphoma such as extranodal T/NK cell lymphoma, nasal type; EBER is negative
- Lymphomatoid papulosis with DUSP22-IRF4 rearrangement: biphasic growth pattern with pagetoid reticulosis-like epidermotropism of small to medium size cerebriform lymphocytes that lack CD30; the second component is dermal or periadnexal and the atypical lymphocytes express CD30+
- Rare forms
- Folliculotropic: perifollicular infiltrate of atypical lymphocytes, cystic dilatation of hair follicle, rupture of hair follicle, hyperplasia of the follicular epithelium, intrafollicular pustules (neutrophil collections) and follicular mucinosis
- Syringotropic: eccrine units with periglandular infiltrate
- Granulomatous: mononuclear infiltrate with perivascular, eccrinotropic and neurotropic distribution associated with noncaseating granulomas
Microscopic (histologic) images
Contributed by Roberto N. Miranda, M.D.
Positive stains
- Activate T helper phenotype (Semin Diagn Pathol 2017;34:22)
Negative stains
- Usually CD8 negative (Semin Diagn Pathol 2017;34:22)
- Variable loss of pan T cell antigens (Semin Diagn Pathol 2017;34:22)
Immunohistochemistry & special stains
Immunohistochemical Summary of LyP Types
*All cases are anaplastic lymphoma kinase - 1 (ALK-1) negative
| Type of LyP | Reference | CD2 | CD3 | CD4 | CD5 | CD7 | CD8 | CD30 | Other markers |
| Type A | Blood 2019;133:1703 | +/- | + | + | +/- | +/- | - | + | TIA1+ |
| Type B | Blood 2019;133:1703 | +/- | + | + | +/- | +/- | - | - | TIA1+ |
| Type C | Blood 2019;133:1703 | +/- | + | + | +/- | +/- | - | + | TIA1+ |
| Type D | Am J Surg Pathol 2010;34:1168 | + | + | - | - | - | + | + | TIA1+, βF1+, CD56-, EBER- |
| Type E | Am J Surg Pathol 2013;37:1 | + | + | -/+ | + | +/- | + | + | CD45RA-, CD45RO+/-, TIA1+, βF1+, EBER- |
| LyP with DUSP22-IRF4 rearrangement | Am J Surg Pathol 2013;37:1173 | +/- | + | - | +/- | +/- | +/- | + | CD15+, TIA1-, Ki67 (> 80%), TCR-β+ |
| Folliculotropic LyP | J Am Acad Dermatol 2013;68:809 | + | + | + | +/- | - | - | + | |
| Granulomatous LyP | Am J Clin Pathol 2003;119:731 | + | + | + | + | - | - | + |
Molecular / cytogenetics description
- Monoclonal rearrangement of the T cell receptor (TCR) is usually detected (Semin Diagn Pathol 2017;34:22)
- Recurrent NPM-TYK2 gene fusion induces activation of STAT signaling pathway (Blood 2014;124:3768)
- DUSP22-IRF4 rearrangement cases have characteristic features (Am J Surg Pathol 2013;37:1173)
- 6p25.3 translocation
- More common in older patients
- Localized lesions and clinical presentation suggesting benign inflammatory dermatoses or epithelial tumors
- Histologically has a bimodal pattern, with epidermotropic cells appearing small and uniform while dermal cells are large and CD30+
Sample pathology report
- Skin of left ear, excisional biopsy:
- CD30 positive T cell lymphoproliferative disorder, with extensive ulceration and necrosis, most consistent with lymphomatoid papulosis (see comment)
- Comment: According to outside pathology report, the patient has a history of left ear abscess. No other clinical history is available at this time.
One routinely stained slide shows four sections of squamous lined tissue with underlying lymphoid neoplasm and minimal remnants of skin that includes sebaceous glands and hair follicle. There is extensive ulceration and a dense diffuse infiltrate of large cells with vesicular nuclei, irregular nuclear outlines and occasional prominent nucleolus. Few mitotic figures are noted. Extensive coagulative necrosis, as well as suppurative necrosis is noted. Rare areas show perivascular viable cells surrounding by extensive necrosis.
The immunohistochemical studies reveal the large neoplastic cells are positive for CD2, CD3, CD4, CD5, CD30 and a subset were positive for CD117 and TIA1. The aberrant cells are negative for CD10, CD20, ALK-1, PAX-5, cytokeratin, CD7, CD8, CD56, ALK and EBER.
The features of this lesion are consistent with primary cutaneous CD30 positive T cell lymphoproliferative disorder, that encompasses lymphomatoid papulosis and cutaneous anaplastic large cell lymphoma. The final diagnosis of this relies on the clinical history. The differential diagnosis includes peripheral T cell lymphoma or ALK negative anaplastic large cell lymphoma with cutaneous involvement or transformation of mycosis fungoides. To exclude these possibilities, clinical correlation and staging studies are recommended.
Differential diagnosis
| LyP Type A | Primary cutaneous anaplastic large cell lymphoma | |
| Reference | Blood 2019;133:1703 | Am J Dermatopathol 2017;39:877 |
| Age | Fifth decade | Seventh decade |
| Gender (M:F) | 2 - 3:1 | 2 - 3:1 |
| Clinical Features | Papular, papulonodular or nodular, < 2 cm | Localized nodule or papule, usually > 2 cm |
| Microscopy | Wedge shaped and large lymphoid infiltrate with neutrophils, eosinophils and histiocytes | Diffuse and uniform dermal infiltrate of anaplastic large cells |
| Immunophenotype | CD3+, CD4+, CD8-, CD30+ | CD3+/-, CD4+, CD8-, CD30+ |
| Treatment | None for spontaneous regression; symptomatic treatment for relief | Excision, radiation or chemotherapy, alone or combined |
| Outcomes | Excellent | Excellent |
| LyP Type B | Early stage mycosis fungoides | |
| Reference | Blood 2019;133:1703 | An Bras Dermatol 2018\;93:546 |
| Age | Fifth decade | Sixth decade |
| Gender (M:F) | 2 - 3:1 | 5:4 |
| Clinical Features | Papular, papulonodular or nodular | Patches and plaques |
| Microscopy | Epidermotropism and band-like distribution of small / medium atypical lymphocytes with cerebriform nuclei (MF-like) | Cerebriform cells with epidermotropism, predominate along basal layer of epidermis |
| Immunophenotype | CD4+, CD8-, CD30- | CD4+, CD7-, CD8-, CD30- |
| Treatment | Spontaneous regression or symptomatic treatment | Ultraviolet light |
| Outcomes | Excellent | Good |
| LyP Type C | Primary cutaneous anaplastic large cell lymphoma | |
| Reference | Blood 2019;133:1703 | Am J Dermatopathol 2017;39:877 |
| Age | Fifth decade | Seventh decade |
| Gender (M:F) | 2 - 3:1 | 2 - 3:1 |
| Clinical Features | Papular, papulonodular or nodular; < 2 cm | Localized nodule or papule, > 2 cm |
| Microscopy | Sheets of large lymphocytes with or without epidermotropism and few admixed inflammatory cells | Diffuse dermal infiltrate of anaplastic morphology |
| Immunophenotype | CD4+, CD8-, CD30+ (uneven) | CD3+/-, CD4+, CD8-, CD30+ (uniform) |
| Treatment | Spontaneous regression or symptomatic treatment | Radiation or chemotherapy, alone or combined |
| Outcomes | Excellent | Good |
| LyP Type D | Primary cutaneous CD8+ aggressive epidermotropic cytotoxic T cell lymphoma | |
| Reference | Am J Surg Pathol 2010;34:1168 | Mod Pathol 2017;30:761 |
| Age | Third decade | Fourth decade |
| Gender (M:F) | 6:3 | 5:2 |
| Clinical Features | Papules and small nodules | Ulcerative patches or plaques |
| Microscopy | Epidermotropism with pagetoid reticulosis-like | Small to intermediate size lymphocytes with epidermotropism |
| Immunophenotype | CD2+, CD3+, CD4-, CD8+, CD30+, TIA1+ | CD2-, CD3+, CD7+, CD8+, CD30-, CD56- |
| Treatment | Spontaneous regression or symptomatic treatment | Chemotherapy, stem cell transplant |
| Outcomes | Excellent | Poor |
| LyP Type E | Extranodal NK/T cell lymphoma, nasal type | |
| Reference | Am J Surg Pathol 2013;37:1 | Blood 2019;133:1703, Curr Hematol Malig Rep 2016;11:514 |
| Age | Sixth decade | Fifth and sixth decade |
| Gender (M:F) | 3:1 | 2:1 |
| Clinical Features | Recurrent papular lesions with rapid progression to hemorrhagic necrotic ulcers | Necrotic lesions |
| Microscopy | Angiocentric and angiodestructive pleomorphic lymphoid infiltrate of small / medium size | Atypical lymphocytes; angiocentric and angiodestructive in most cases |
| Immunophenotype | CD2+, CD3+, CD4-/+, CD8+, CD30+, TIA1+ | CD3-, CD4-, CD5-, CD8-, CD30+, CD56+, TIA1+, EBER+ |
| Treatment | Spontaneous regression or symptomatic treatment | Progressive disease |
| Outcomes | Excellent | Poor |
| LyP with DUSP22-IRF4 rearrangement | Transformed mycosis fungoides | |
| Reference | Am J Surg Pathol 2013;37:1173 | Pathology 2014;46:610 |
| Age | Eighth decade | Seventh decade |
| Gender (M:F) | 9:2 | 1.1:1 |
| Clinical Features | One or multiple eruptive and papulonodular lesions in a single body area | Patches, plaques and tumor |
| Microscopy | Biphasic growth pattern and epidermotropism and periadnexal small to medium size cerebriform cells | Cerebriform with increased large cells in dermis |
| Immunophenotype | CD3+, CD4-, CD8+/- | CD3+, CD4-, CD7-, CD8-, CD30+/- |
| Treatment | Spontaneous regression or symptomatic treatment | Radiation, chemotherapy |
| Outcomes | Excellent | Poor |
| Folliculotropic LyP | Folliculitis | |
| Reference | J Am Acad Dermatol 2013;68:809 | Folliculitis |
| Age | Sixth decade | Variable |
| Gender (M:F) | 9:2 | Variable |
| Clinical Features | Follicular pustules | Superficial folliculitis |
| Microscopy | Perifollicular infiltrate of atypical lymphocytes and follicular mucinosis | Moderate mixed inflammatory cells in the follicular ostium |
| Immunophenotype | CD3+, CD4+, CD30+ | Nonclonal |
| Treatment | Spontaneous regression | Topical treatment |
| Outcomes | Excellent | Excellent |
| Granulomatous LyP | Discoid lupus erythematous | |
| Reference | Am J Clin Pathol 2003;119:731 | Arch Dermatol 2009;145:249 |
| Age | Fifth decade | Fifth decade |
| Gender (M:F) | 5:4 | 1:2 |
| Clinical Features | Nodules | Discoid lesions |
| Microscopy | Noncaseating granulomas associated with mononuclear infiltrate with perivascular, eccrinotropic and neurotropic distribution | Edema and a mild infiltrate of inflammatory cells (lymphocytes) in upper dermis |
| Immunophenotype | CD3+, CD4+, CD5-, CD7-, CD8-, CD30+ | CD3+, CD4+; no loss of T cell antigens |
| Treatment | Spontaneous regression | Systemic agents, Phototherapy |
| Outcomes | Excellent | Excellent |
Additional references
Practice question #1
Which is the rearrangement that defines a type of lymphomatoid papulosis?
- ETV6-ABL
- EML4-ALK
- DUSP22-IRF4
- NPM-TYK2
Practice answer #1
Practice question #2
Which LyP types are usually associated with a cytotoxic phenotype?
- Type A and B
- Type B and C
- Type C and D
- Type D and E
Practice answer #2